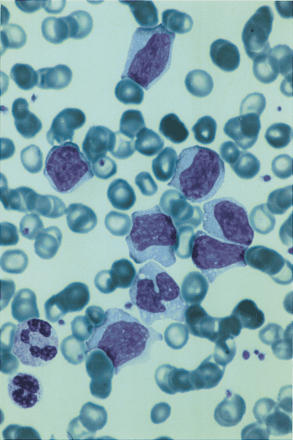
issue cover

Skip Nav Destination
Phase 2 study of alemtuzumab (anti-CD52 monoclonal antibody) in patients with advanced mycosis fungoides/Sézary syndrome
Rituximab plus CHOP (R-CHOP) overcomes bcl-2—associated resistance to chemotherapy in elderly patients with diffuse large B-cell lymphoma (DLBCL)
Impaired recovery of Epstein-Barr virus (EBV)—specific CD8+ T lymphocytes after partially T-depleted allogeneic stem cell transplantation may identify patients at very high risk for progressive EBV reactivation and lymphoproliferative disease
Inhibition of coagulation, fibrinolysis, and endothelial cell activation by a p38 mitogen-activated protein kinase inhibitor during human endotoxemia
ADAMTS13 gene mutation in congenital thrombotic thrombocytopenic purpura with previously reported normal VWF cleaving protease activity
Issue Archive
June 1 2003
Table of Contents
INSIDE BLOOD
BLOOD WORK
REVIEW ARTICLES
CHEMOKINES
CLINICAL OBSERVATIONS, INTERVENTIONS, AND THERAPEUTIC TRIALS
Phase 2 study of alemtuzumab (anti-CD52 monoclonal antibody) in patients with advanced mycosis fungoides/Sézary syndrome
Clinical Trials & Observations
Jeanette Lundin,Hans Hagberg,Roland Repp,Eva Cavallin-Ståhl,Susanne Fredén,Gunnar Juliusson,Eija Rosenblad,Geir Tjønnfjord,Tom Wiklund,Anders Österborg
Rituximab plus CHOP (R-CHOP) overcomes bcl-2—associated resistance to chemotherapy in elderly patients with diffuse large B-cell lymphoma (DLBCL)
Clinical Trials & Observations
Nicolas Mounier,Josette Briere,Christian Gisselbrecht,Jean-Francois Emile,Pierre Lederlin,Catherine Sebban,Francoise Berger,Andre Bosly,Pierre Morel,Herve Tilly,Reda Bouabdallah,Felix Reyes,Philippe Gaulard,Bertrand Coiffier
Impaired recovery of Epstein-Barr virus (EBV)—specific CD8+ T lymphocytes after partially T-depleted allogeneic stem cell transplantation may identify patients at very high risk for progressive EBV reactivation and lymphoproliferative disease
Clinical Trials & Observations
Pauline Meij,Joost W. J. van Esser,Hubert G. M. Niesters,Debbie van Baarle,Frank Miedema,Neil Blake,Alan B. Rickinson,Ingrid Leiner,Eric Pamer,Bob Löwenberg,Jan J. Cornelissen,Jan W. Gratama
GENE THERAPY
HEMATOPOIESIS
HEMOSTASIS, THROMBOSIS, AND VASCULAR BIOLOGY
The low-frequency allele of the platelet collagen signaling receptor glycoprotein VI is associated with reduced functional responses and expression
Lotta Joutsi-Korhonen,Peter A. Smethurst,Angela Rankin,Elaine Gray,Martin IJsseldijk,Catherine M. Onley,Nicholas A. Watkins,Lorna M. Williamson,Alison H. Goodall,Philip G. de Groot,Richard W. Farndale,Willem H. Ouwehand
A novel genetic leukocyte adhesion deficiency in subsecond triggering of integrin avidity by endothelial chemokines results in impaired leukocyte arrest on vascular endothelium under shear flow
Ronen Alon,Memet Aker,Sara Feigelson,Maya Sokolovsky-Eisenberg,Donald E. Staunton,Guy Cinamon,Valentin Grabovsky,Revital Shamri,Amos Etzioni
Inhibition of coagulation, fibrinolysis, and endothelial cell activation by a p38 mitogen-activated protein kinase inhibitor during human endotoxemia
Clinical Trials & Observations
Brief Report
Judith Branger,Bernt van den Blink,Sebastiaan Weijer,Abhya Gupta,Sander J.H. van Deventer,C. Erik Hack,Maikel P. Peppelenbosch,Tom van der Poll
ADAMTS13 gene mutation in congenital thrombotic thrombocytopenic purpura with previously reported normal VWF cleaving protease activity
Clinical Trials & Observations
Brief Report
IMMUNOBIOLOGY
NEOPLASIA
MALT1 is deregulated by both chromosomal translocation and amplification in B-cell non-Hodgkin lymphoma
Dolors Sanchez-Izquierdo,Gerard Buchonnet,Reiner Siebert,Randy D. Gascoyne,Joan Climent,Loraine Karran,Miguel Marin,David Blesa,Douglas Horsman,Andreas Rosenwald,Louis M. Staudt,Donna G. Albertson,Ming-Qing Du,Hongtao Ye,Peter Marynen,Javier Garcia-Conde,Daniel Pinkel,Martin J. S. Dyer,Jose Angel Martinez-Climent
PHAGOCYTES
RED CELLS
TRANSFUSION MEDICINE
CORRESPONDENCE
-
Cover Image
Cover Image
![issue cover]()
Advertisement intended for health care professionals
Email alerts
Advertisement intended for health care professionals